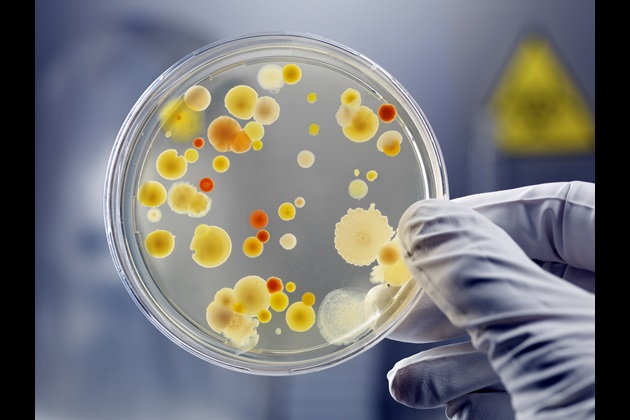

Imagine health care without effective antibiotics. In many cultures that’s the norm but in the UK and other developed countries it’s hard to conceive of some diseases and infections being treated any other way.
Yet antimicrobial resistance (AMR) is a growing threat to global public health. The World Health Organisation says, for example, that in 2016 nearly half a million people worldwide developed multi-drug-resistant tuberculosis. The fight against HIV and malaria is also being compromised.
Dr Colin Macduff is an RCN member who, with research colleagues, is encouraging nursing staff to think about how they respond to this challenge. Their approach is innovative, as Colin’s place of work might suggest. He’s currently senior research fellow at Glasgow School of Art.
A different approach
Campaigns to raise awareness of AMR have usually been top-down, government-led. But the project Colin heads – Re-envisaging Infection Practice Ecologies in Nursing (RIPEN) – adopts a different method and considers how arts and humanities can play a part.
Colin’s collaboration with researchers from other disciplines grew from his interest in “dynamic visualisation” as a means of exploring health care workers’ perceptions of pathogens. Modelling and mapping these, and combining them with scientific data on infection risk, produces information that is easier for staff to relate to as they move around a clinical space, helping them “visualise the invisible”.
But RIPEN is now researching ways in which history, design, art and drama, as well as visualisation and nursing and health research, can play a part in developing practice in relation to AMR.
“There are two strands to the project,” Colin says. “The first involves two workshops with nurses, looking at what people do and their ideas for improving practices relating to AMR. The second is around what happens if things don’t go well. Can we imagine nursing with very few antibiotics?”
A daunting future
The second question exposes a gap in the literature, Colin says. “Very few nurses have envisaged a future without antibiotics, probably because it’s daunting. With few or no functioning antibiotics, routine surgery for all sorts of conditions would no longer be feasible.”
With few or no functioning antibiotics, routine surgery for all sorts of conditions would no longer be feasible
RIPEN researchers are now recruiting community and hospital-based nursing staff to participate in the workshops, to be held in Glasgow and London, where the study questions will be explored using mainly visual methods.
Rose Gallagher, RCN Professional Lead for Infection Prevention and Control, urges members to consider taking part. “The work Colin and the RIPEN team are doing is vitally important. They’re using innovative methods to get us all thinking hard about AMR and its potentially devastating implications. I’m looking forward to seeing the project’s outcomes.”
RIPEN’s final stage will be a Policy Lab event where the research team will present stakeholders with the implications of the project and priorities for action. “Some of the outcomes will be quite small things that people can incorporate into their practice,” Colin says. “But another part will be how nurses envisage working with fewer antibiotics, and what the challenges and some of the creative solutions might be. These are big issues and we’re hoping to shed some light and stimulate policy discussion.”